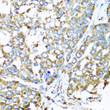
Immunohistochemistry analysis of paraffin-embedded human liver cancer using COX6A1 antibody (STJ26481) at dilution of 1:100 (40x lens). Perform microwave antigen retrieval with 10 mM PBS buffer pH 7. 2 before commencing with immunohistochemistry staining protocol.

Anti-COX6A1 antibody (25-109) (STJ26481)
SPECIFICATIONS
ClonalityPolyclonal
HostRabbit
ConjugationUnconjugated
IsotypeIgG
General Information
| Short Description | Rabbit polyclonal COX6A1 (25-109) antibody for use in WB, IHC-P, IF, ICC and ELISA in human, mouse and rat samples. Datasheet included with dilution recommendations, and related reagents. |
| Applications | WB/IHC-P/IF/ICC/ELISA |
| Host | Rabbit |
| Reactivity | Human/Mouse/Rat |
| Note | STRICTLY FOR FURTHER SCIENTIFIC RESEARCH USE ONLY (RUO). MUST NOT TO BE USED IN DIAGNOSTIC OR THERAPEUTIC APPLICATIONS. |
Product Properties
| Clonality | Polyclonal |
| Isotype | IgG |
| Conjugation | Unconjugated |
| Concentration | Lot specific |
| Purification | Affinity purification |
| Dilution Range | WB:1:200-1:2000IHC-P:1:20-1:200IF/ICC:1:50-1:200ELISA:Recommended starting concentration is 1 Mu g/mL. Please optimize the concentration based on your specific assay requirements. |
| Formulation | PBS with 0.02% Sodium Azide, 50% Glycerol, pH 7.3. |
| Storage Instruction | Store at-20°C for up to 1 year from the date of receipt, and avoid repeat freeze-thaw cycles. |
Target Information
| Gene Symbol | COX6A1 |
| Gene ID | 1337 |
| Uniprot ID | CX6A1_HUMAN |
| Immunogen Region | 25-109 |
| Immunogen Sequence | SSGAHGEEGSARMWKTLTFF VALPGVAVSMLNVYLKSHHG EHERPEFIAYPHLRIRTKPF PWGDGNHTLFHNPHVNPLPT GYEDE |
| Specificity | Recombinant fusion protein containing a sequence corresponding to amino acids 25-109 of human COX6A1 (NP_004364.2). |
Additional Info
| Function | Component of the cytochrome c oxidase, the last enzyme in the mitochondrial electron transport chain which drives oxidative phosphorylation. The respiratory chain contains 3 multisubunit complexes succinate dehydrogenase (complex II, CII), ubiquinol-cytochrome c oxidoreductase (cytochrome b-c1 complex, complex III, CIII) and cytochrome c oxidase (complex IV, CIV), that cooperate to transfer electrons derived from NADH and succinate to molecular oxygen, creating an electrochemical gradient over the inner membrane that drives transmembrane transport and the ATP synthase. Cytochrome c oxidase is the component of the respiratory chain that catalyzes the reduction of oxygen to water. Electrons originating from reduced cytochrome c in the intermembrane space (IMS) are transferred via the dinuclear copper A center (CU(A)) of subunit 2 and heme A of subunit 1 to the active site in subunit 1, a binuclear center (BNC) formed by heme A3 and copper B (CU(B)). The BNC reduces molecular oxygen to 2 water molecules unsing 4 electrons from cytochrome c in the IMS and 4 protons from the mitochondrial matrix. |
| Protein Name | Cytochrome C Oxidase Subunit 6a1 - MitochondrialCytochrome C Oxidase Polypeptide Via-LiverCytochrome C Oxidase Subunit Via-LiverCox Via-L |
| Database Links | Reactome: R-HSA-5628897Reactome: R-HSA-611105Reactome: R-HSA-9707564Reactome: R-HSA-9864848 |
| Cellular Localisation | Mitochondrion Inner MembraneSingle-Pass Membrane Protein |
| Alternative Antibody Names | Anti-Cytochrome C Oxidase Subunit 6a1 - Mitochondrial antibodyAnti-Cytochrome C Oxidase Polypeptide Via-Liver antibodyAnti-Cytochrome C Oxidase Subunit Via-Liver antibodyAnti-Cox Via-L antibodyAnti-COX6A1 antibodyAnti-COX6AL antibody |
Information sourced from Uniprot.org